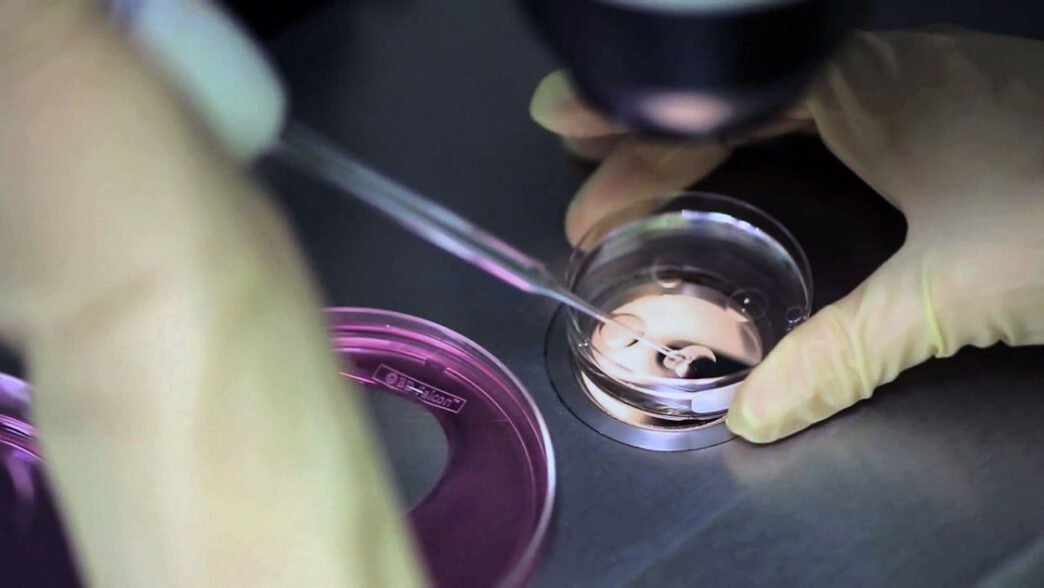
Tüp Bebek Tedavisinde Embriyolar

Bilim insanları, tüp bebek tedavisinde çığır açabilecek bir gelişmeye imza attı. İngiltere’de Cambridge Üniversitesi ve ABD’de Rockefeller Üniversitesi’nden uzmanlar, embriyoları laboratuvar ortamında 13 gün boyunca büyütmeyi başardı.
Bu gelişme, tüp bebek tedavisinde başarı oranlarını artırabilecek önemli bir ilerleme olarak değerlendiriliyor. Özellikle bebek sahibi olamayan çiftler için büyük bir umut kaynağı olacağı belirtiliyor.
Tüp Bebek Tedavisinde Yeni Dönem
Mevcut uygulamalarda döllenmiş yumurtalar laboratuvar ortamında en fazla 5 gün boyunca saklanabiliyordu. Embriyoların sağlıklı gelişimi için en geç 7. gün içinde rahme transfer edilmesi gerekiyordu.
Ancak geliştirilen yeni teknik sayesinde, döllenmiş yumurtalar özel bir kimyasal karışım içinde 13 gün boyunca laboratuvarda büyütülebiliyor. Bu sayede, embriyonun gelişim süreci daha ayrıntılı incelenebiliyor ve gebelik başarı oranları artırılabiliyor.
Embriyo Gelişiminde Kritik Aşama: 14. Gün
Embriyoların gelişimi açısından kritik bir dönemeç olan 14. gün, organların temelini oluşturan tabakaların gelişmeye başladığı gastrulasyon evresine geçiş dönemi olarak biliniyor. Bu aşamada, embriyonun cilt, kas, omurga, beyin ve iç organlarına dönüşecek dokuların temelleri atılıyor.
Bu süreci laboratuvar ortamında gözlemlemek, erken gebelik kayıplarının nedenlerini daha iyi anlamaya yardımcı olabilir.
Cambridge Üniversitesi’nden memeli gelişimi ve kök hücre biyolojisi uzmanı Profesör Magdalena Zernicka-Goetz, bu gelişmenin embriyonun rahimde nasıl büyüdüğüne dair benzersiz bilgiler sunduğunu belirtti. Zernicka-Goetz, özellikle yumurtanın rahme nakledilme sürecinin gebelik kayıplarının başlıca nedenlerinden biri olduğunu vurguladı.
Bilimsel Çalışmalar ve Etik Tartışmalar
Bu önemli araştırma, bilim dünyasının önde gelen dergileri Nature ve Cell Biology‘de yayımlandı. Çalışmada kullanılan embriyolar, tüp bebek tedavisi gören çiftler tarafından gönüllü bağış yoluyla sağlandı.
Ancak, bu gelişme bazı etik tartışmaları da beraberinde getirdi. Embriyoların laboratuvarda daha uzun süre tutulması, “İleride bebekler laboratuvarda mı doğacak?” gibi soruları gündeme getirdi. Uluslararası bilim çevrelerinde 14. gün kuralı, embriyoların laboratuvarda büyütülmesi için kabul edilen etik sınır olarak değerlendiriliyor.
Profesör Zernicka-Goetz ise bu tür spekülasyonlara yanıt vererek, bunun henüz bilim kurgu seviyesinde bir senaryo olduğunu ve embriyoların tamamen laboratuvar ortamında büyütülmesinin fazlasıyla uzak bir ihtimal olduğunu ifade etti.
Bu Gelişme Ne Anlama Geliyor?
Bu önemli bilimsel ilerlemenin tüp bebek tedavisindeki etkileri şöyle özetlenebilir:
- Gebelik başarı oranları artabilir: Embriyonun rahme tutunma sürecinin daha iyi anlaşılmasıyla daha yüksek başarı oranları sağlanabilir.
- Erken gebelik kayıplarının önüne geçilebilir: Hamileliğin ilk aşamalarında yaşanan kayıpların sebepleri daha detaylı araştırılabilecek.
- Yeni tüp bebek teknikleri geliştirilebilir: Embriyonun daha uzun süre laboratuvarda gelişimini sağlamak, yeni yardımcı üreme tekniklerinin yolunu açabilir.
Gelecekte Neler Bekleniyor?
Bilim insanları, embriyonun gelişim sürecinin daha iyi anlaşılması için çalışmalara devam ediyor. Araştırmalar, tüp bebek uygulamalarının daha güvenli ve başarılı hale gelmesi açısından büyük önem taşıyor.
Ancak etik sınırlar dikkate alınarak yapılacak yeni çalışmaların, tüp bebek tedavisindeki ilerlemeleri nasıl şekillendireceği zamanla daha net ortaya çıkacak.